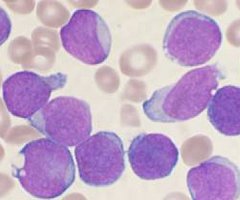
Demostrada la relación de dos oncogenes con la frecuencia de leucemias en ratones

2014
-
-
-
-
IV Reunión Científica Regional de la Asociación Argentina de Ciencia y Tecnología de Animales de Laboratorio (AACyTAL), 22 al 24 de septiembre, Buenos Aires, Argentina.
05 October 2014Cuando recibí la invitación para participar como disertante en el IV Congreso de AACyTAL sentí una alegría inmensa, era una oportunidad única de reencontrarme con colegas y amigos que hacía tiempo que no veía. Como condimento extra hacía casi dos años que no visitaba mi país.
-
Dosis de hormona recomendada para superovular ratas Sprague Dawley
02 September 2014 -
-
Cómo convertir los malos recuerdos en buenos
28 August 2014 -
Nueva esperanza contra el mal de Chagas
18 August 2014 -
-